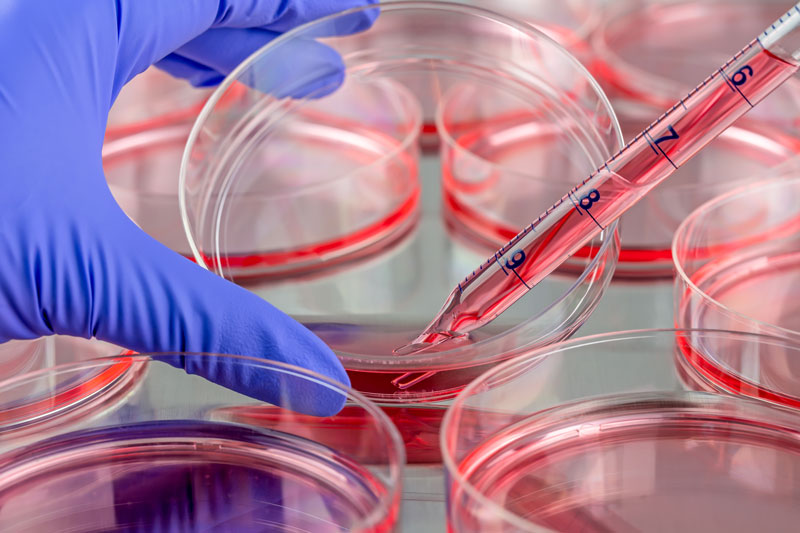
Custom cell lines development - InvivoGen Custom cell lines development - InvivoGen

InvivoGen was founded in 1977 by a team of scientists whose technical expertise and creative excellence stem from a longstanding history in microbiology. As specialists in innate immunity and cell culture, we offer high quality products that guarantee robust and reproducible data including PRR ligands, cell lines, selective antibiotics, antimicrobial agents, vaccine adjuvants, and antibodies.
Featured product categories
New products
Featured products
Need custom services ?

Cytokines Compound Screening
Our profiling service enables the detection of bioactive effects in your samples.

PRR Compound Screening and Profiling
Our screening service can assess activation or inhibition of innate immune pathways by pattern recognition receptors
Custom Cell Line Development Service
Our custom cell line development service is designed to support your specific experimental goals

Custom Cloning Service
Specialized plasmids designed to meet your unique experimental needs
About InvivoGen
The heart of InvivoGen’s culture and commitment is to provide life scientists with high quality and reliable reagents to make key discoveries possible.


InvivoGen
USA
10515 Vista Sorrento Pkwy 92121
San Diego United States
Tel 888 457 5873

InvivoGen
Europe
5, rue Jean Rodier 31400
Toulouse France
Tel +33 (0)5.62.71.69.39

InvivoGen
Asia
Unit 307, 3rd Floor, Building 8W, Phase Two, Hong Kong Science Park, Pak Shek Kok
Hong Kong SAR China
Tel +852-36223480


















